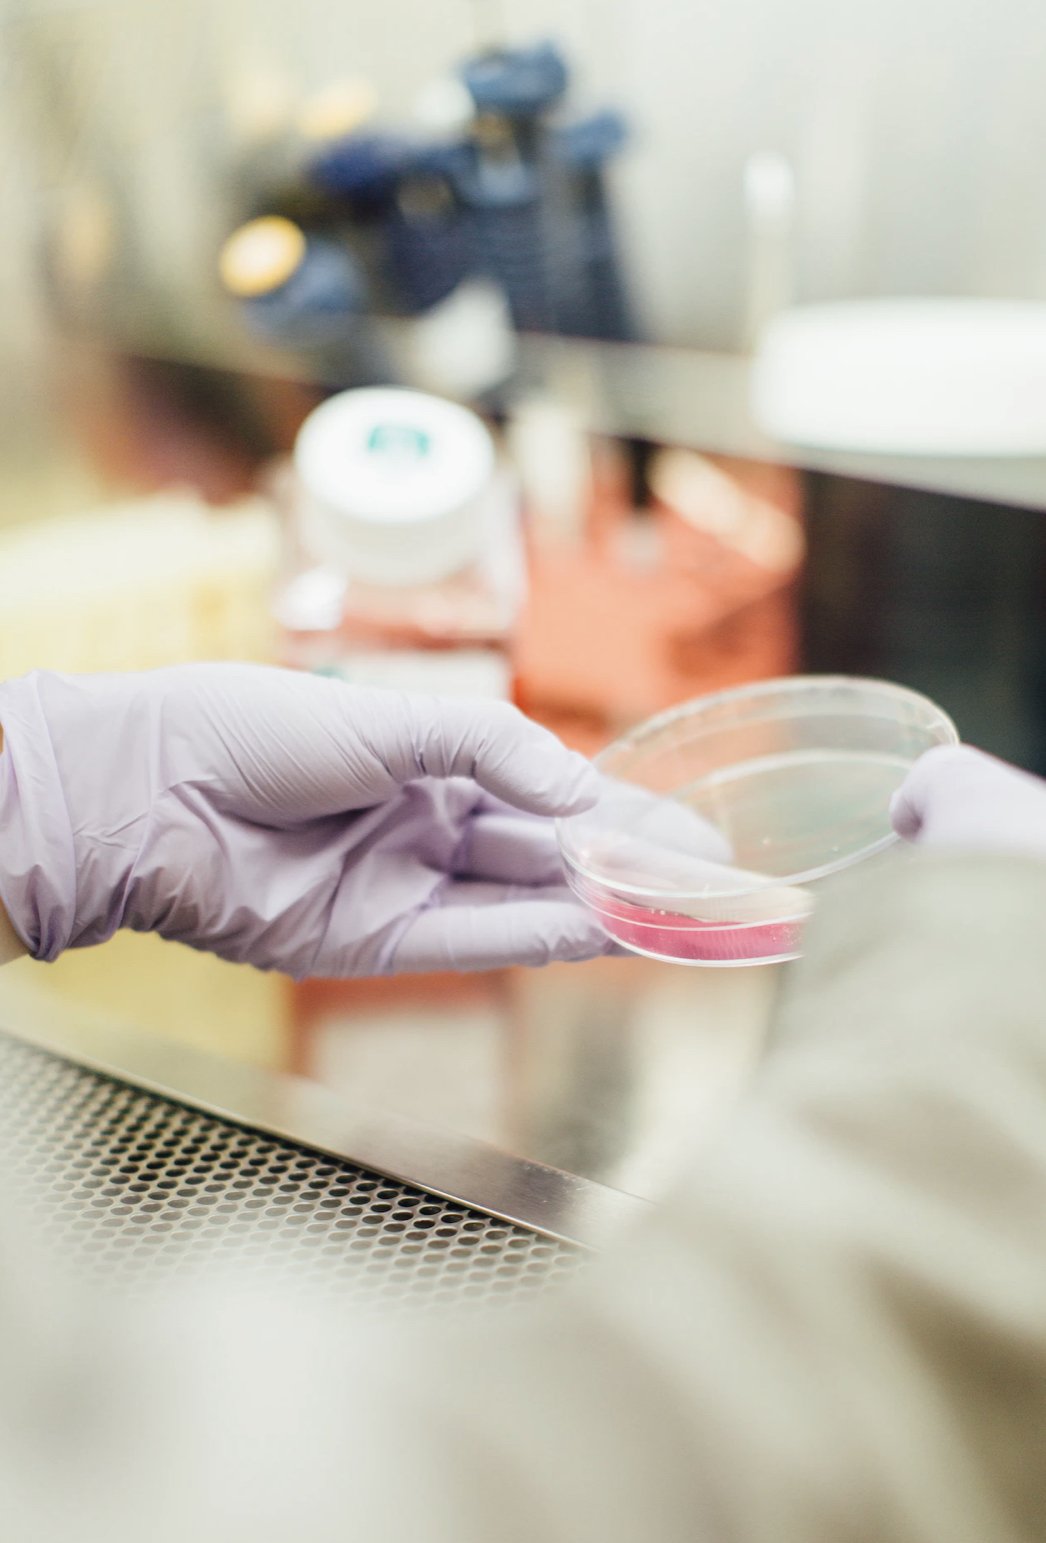

Design Work
“Design work” here is in reference to any work made under the instruction of a client or company.
Below are creative approaches to design work with considerations of
marketing * brand identity * layout * print and shipping * gif and video animation * social media creation
Brand/Mural Work
FIESTA HILL MEXICAN BAR AND GRILL
Svetlana created the brand logo, identity, website, and murals.

Visual Design
JEMA, Architects
Svetlana worked as the Visual Designer for JEMA, an architecture and interior design firm based in St. Louis, MO.

Svetlana was visual art director for Epic Magazine. Outside of the magazine itself, she was also responsible for laying out and printing posters, flyers, and social media content.
Svetlana did the logo concept, final logo designing, iterations and the brand visual strategy for Health Communication Research Center.